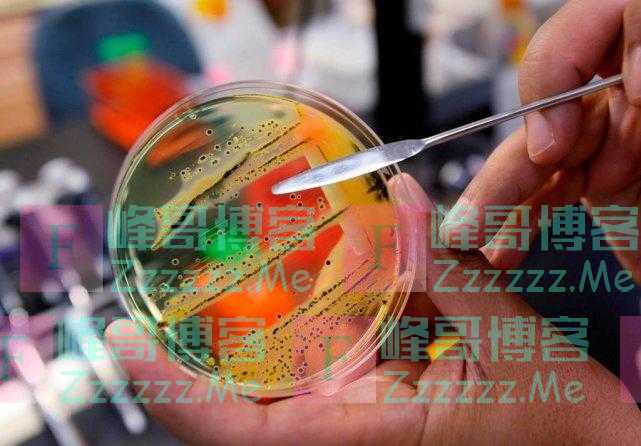

据美国福克斯新闻网27日报道,美国卫生官员警告称,来源不明的沙门氏菌疫情已经蔓延到美国29个州。

根据美国疾病控制与预防中心(CDC) 9月23日发布的最新消息,这一波疫情已经感染了近280人,超过24人已住院治疗。
不过,CDC称,目前还没有与“快速暴发的疫情”有关联的死亡病例。
该机构绘制了一张地图,展示了受沙门氏菌疫情影响的人们的居住地。到目前为止,得克萨斯州报告的病例最多,为81例,其次是伊利诺伊州和弗吉尼亚州,分别报告了23例和22例病例。明尼苏达州(19例)和马萨诸塞州(10例)成为报告病例最多的第四名和第五名。
然而,CDC警告说,这幅地图可能并未完全统计所有的病例,“因为许多人没有接受医疗护理就康复了,也没有进行沙门氏菌检测。”

CDC表示,几个州的官员一直在收集数据,调查沙门氏菌疫情的暴发。官员们一直在收集和检测“病人吃过的”餐馆的食品,但尚未确定与疫情有关联的食品。
在最新的更新中,CDC表示,在一个装有香菜和酸橙的外卖调味杯中发现了一种“奥拉尼堡沙门氏菌”,但容器中也含有洋葱,因此很难确定来源。
CDC表示:“由于容器和检测样本中存在多种食品,无法得知是哪一种食品受到了污染。”
官员们正在利用这些信息“结合其他可用信息,帮助缩小与疾病有关的可能食物清单”。
根据CDC的数据,这种潜在的有害细菌每年在美国造成约135万人感染,26500人住院,420人死亡。大多数感染这种细菌的人会出现腹泻、发烧和胃痉挛等症状,这些症状最长会持续7天。然而,CDC表示,在某些情况下,“人们的病情可能非常严重,需要住院治疗。”
(编辑:ZLQ)
文章如无特别注明均为原创!
作者:
F_Robot,
转载或复制请以
超链接形式 并注明出处 峰哥博客。
原文地址《
又一种疫情在美国暴发!已蔓延至29州,感染者腹泻、发烧、胃痉挛》发布于2021-9-29
若您发现软件中包含弹窗广告等还请第一时间留言反馈!
小米手机无法安装请到设置->开发者设置->关闭系统优化,安装后再开启系统优化。





